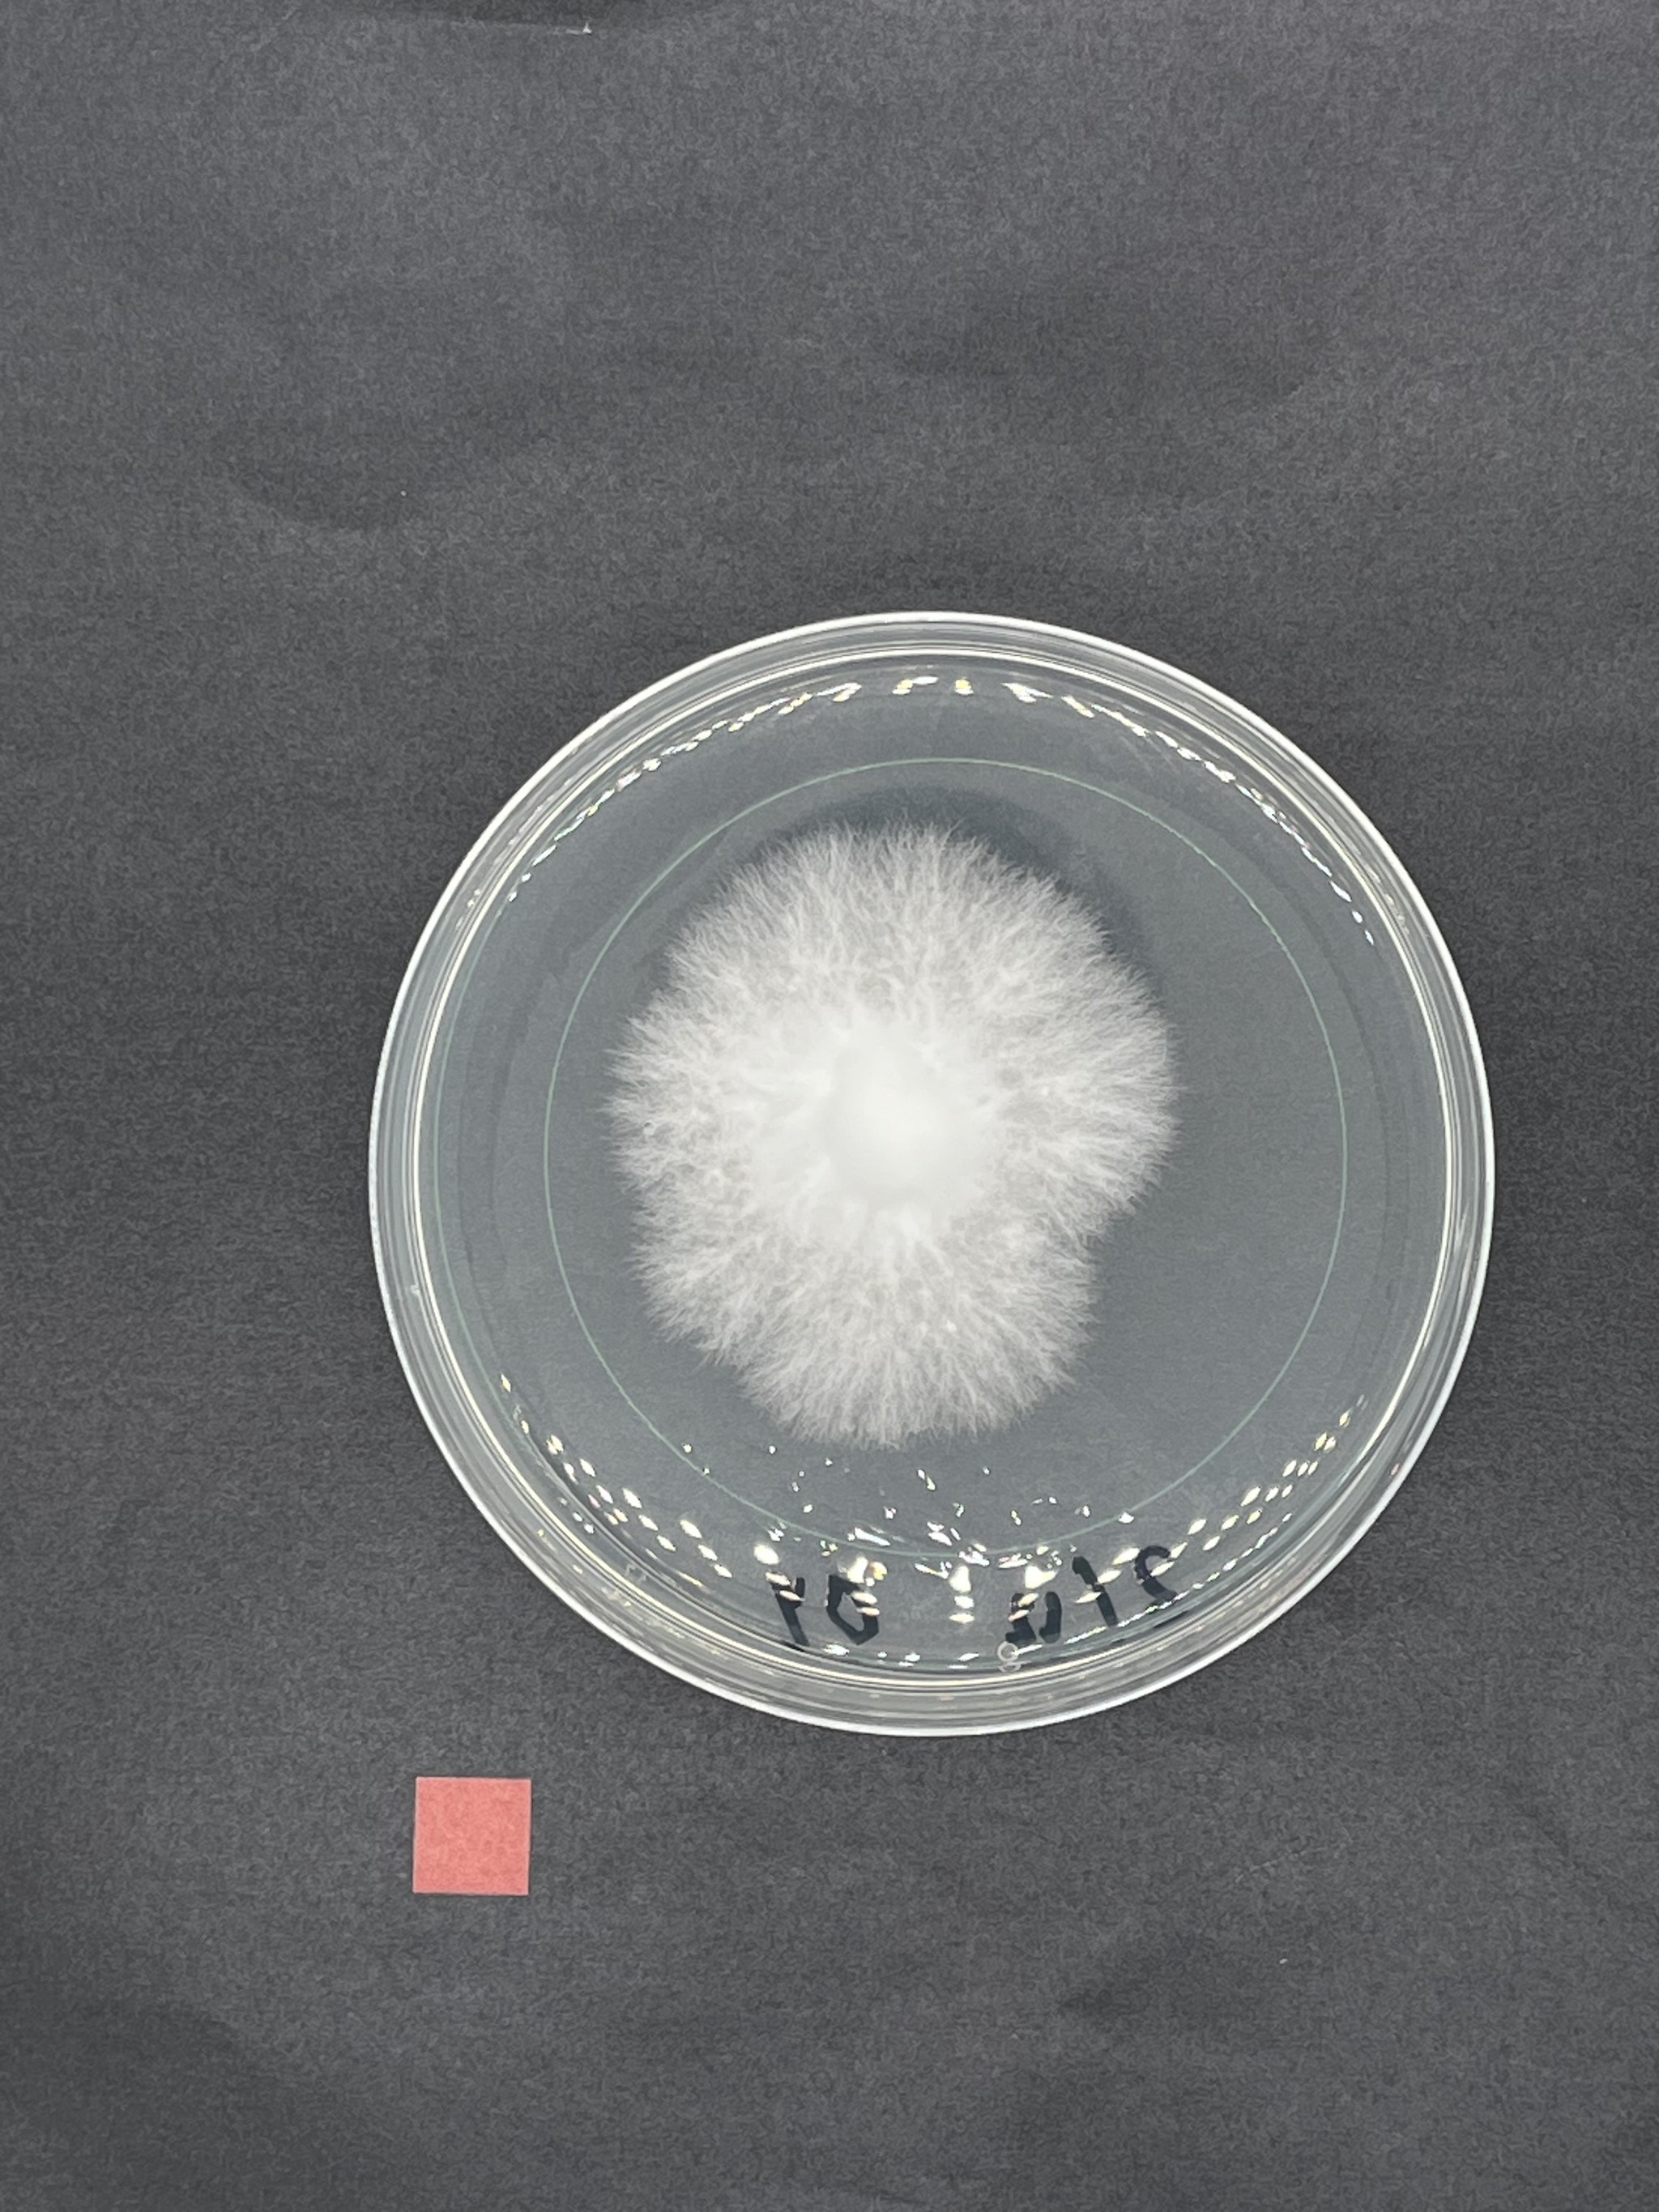

Development
Creativity & Aesthetics
"Aesthetics is the language of objects and artifacts"
Creativity and aesthetics (C&A) are of the utmost importance in design. I see aesthetics as the language of objects and artifacts. It shapes how users perceive, feel, and interact with those objects and artifacts, by utilizing different modality’s like shape, haptics, sound and temporality. It is our main way of making a design “speak” to its users. To communicate through your design properly, a designer needs to speak this language fluently. Having something looking good also communicates professionality. It makes a product say: a lot of time and attention went into creating this. It creates engagement. Creativity for me refers to one’s ability to select interesting insights and existing concepts to combine and apply them in novel creative ways.
I developed C&A the most during aesthetics of interaction, where we created Bullai. In this project, I explored aesthetics by combining character-based design with experiential prototyping. The concept was inspired by the abstract perception of time and the rustic aesthetic of a fictional sailor persona called Davie Jones. I practiced combining interesting insights and existing concepts into novel creative ways, by mood boarding, soundscaping, and interaction relabeling. Our group created a prototype that proposed a different perspective on time through physical interaction and narrative form. This project taught me how to use aesthetic elements like material, motion, and metaphors to shift perspectives.
In my FBP “Thermocelium” I also used aesthetics as a language to shift perception. The artifact was designed to communicate through its form, material, and behavior. The slow, organic growth of the Reishi mycelium became a temporal and visual expression of heat, inviting users to reflect on smartness, and co-habitation. The design used subtle cues in shape, colour and temporality to speak to users in a more-than-human context, achieving to weaken social scripts.
I have learned to craft experiences that resonate with users by using different modalities of aesthetics. My creative process allows me to combine insights and references in original ways. It helps me navigate ambiguity and bring depth to my work. Ultimately, it allows me to design artifacts that not only function well but also speak clearly and compellingly to those who engage with them.
Technology & Realization
"Making, building, and crafting. It is a core part of who I am!"
If aesthetics is the language of objects, then technology and realization (T&R) is the ability to write. T&R turns ideas into working prototypes and involves mastering tools, crafts and material knowledge. An extensive knowledgebase and skillset of how to make things helps designers to be more creative and to convey ideas more accurately. It enables designers to make their idea’s tangible.
I love making, building, and crafting. It is a core part of who I am and has shaped my development as a designer. Next to the standard courses creative electronics and creative programming, I also took the course creative mechanical design/engineering/manufacturing advanced. Throughout my bachelor’s, I actively sought out opportunities to build and prototype. In projects 1, 2, 3 and A.O.I., I was responsible for the technical realization of our concepts, learning to work with Arduino, sensors, and electronics. I became comfortable with designing and assembling functional systems.
Although I really like working with physical materials, computer based prototyping can also be very fun and powerful. I mainly used c++ and Processing and Unity to create multiple digital interfaces. A good example is project 1 18+ where I build a functioning card reader and online payment system.
I worked for a year as a production assistant at the light art studio Studio Toer. During this time, I further developed my skills in working with Arduino, electrical circuits, soldering, and stainless steel. Sometimes, I was even able to give advice to the lead designers on how to solve electronical bugs in their artwork. Collaborating closely with Akko Goldenbeld and working on Candles, I learned many subtle techniques involved in crafting mechanical artifacts. This experience also gave me a clear understanding of the difference between building a high-fidelity prototype for concept demonstration and creating a robust, commercially viable artifact designed to function reliably over extended periods.
During my B3.1 research, I deepened my technical skills by working in a bio-lab, where I learned sterile techniques, designed custom inoculation tools, and introduced myself to 3D scanning and printing, and laser cutting to support biological experimentation. These experiences taught me how to work precisely, adapt to material constraints, and develop tools that support both scientific and design goals.
All of this came together in Thermocelium. I applied my knowledge of tech and crafts to create a series of functional prototypes. I developed a casing that supported fungal growth while allowing for visibility and interaction. I experimented with different substrates and moisture-retention, drawing on what I had learned in the lab. I also integrated biological and mechanical components into a cohesive system that responded to environmental conditions. This project challenged me to balance technical precision with organic unpredictability, and it showed me how making can be a way of thinking, testing, and communicating. Through this process, I became confident in my ability to realize complex, hybrid systems that combine living materials with designed structures.
User & Society
"How can we create true value?"
If you use design as a way to philosophize, than this area dictates what questions you ask, and why you ask them. This expertise area is about giving your design purpose. In order to create true value for your intended user, it is important to understand them fully. This expertise area is about a designer’s ability to understand the needs and wants of all entities that interact with your artifacts, not just people, but also non-human users such as living organisms. It is also about ethics, and the broader societal impact of your design. Designers can do this by analysing societal trends, behavioural patterns of users, and placing themselves in the shoes of the users they are designing for.
I developed skills in user and society (U&S) through the standard courses user centred design, < design research > and the elective Socio-cultural Sensitivity.
This expertise areas
Almost all of my projects touched U&S somehow. It was a big topic in project 1 (18+) but I got a deeper understanding of it in project 2 Co-Ba. Together with Femke Schaap, I designed a breakroom experience to address collective stress in office environments. During this project, I practiced co-creation sessions, expert interviews, and implementation of ambient feedback to support both individual well-being and systemic awareness about stress. This project taught me how to facilitate group ideation, conduct empathy mapping, and design for emotional and social dynamics in shared spaces.
I think that in design research projects, U&S is also very important, for the social relevance of your research. In Project 3 we developed a personalized fruit delivery system, using a smart fruit bowl that tracked consumption patterns. We conducted multi-phase user testing including probe studies, in-home trials, and interviews. This project helped me understand behavioural patterns around food waste and taught me how to design services that balance automation with user autonomy. It also introduced me to ethical considerations regarding data collection in domestic environments.
My FBP was a research design project that explored integration of fungi as a way to rethink smartness and user interaction. By living with the artifact myself, I investigated how a living organism could be seen not just as material, but as an intelligent agent and co-participant. This approach challenged dominant cultural scripts about cleanliness, control, and intelligence.
The project used speculative design and public engagement to provoke reflection on how we relate to living systems. It questioned assumptions embedded in everyday technology and invited users to consider slower, more relational forms of interaction. Thermocelium became a tool for cultural critique, using design to shift perspectives and open up dialogue about more-than-human futures.
Business & Entrepreneurship
"How will I be able to sustain my design practices?"
Business and entrepreneurship (E&B) enables designers to bring their ideas into the world in a sustainable and impactful way. It’s about more than just monetization. It’s about understanding how to position, scale, and sustain a concept, while staying true to its values. This area also includes managing projects and teams in a designedly fashion, using strategic tools to align creative vision with real-world viability.
Throughout my bachelor’s, I actively sought out opportunities to develop my entrepreneurial mindset. I followed the Technology and Entrepreneurship USE line and chose electives to help me explore and shape my business ideas. One of the most formative experiences was the Design Management elective, where I co-developed a platform concept called Design Hive. This platform aimed to connect designers with clients more meaningfully and efficiently. Our concept was selected as the most promising in the course. In this project I used various strategic tools and methods, including: Business Model Canvas to map out and identify business structures and then systematically iterate on it. SWOT Analysis to evaluate internal strengths and weaknesses against external opportunities and threats. Value Proposition Canvas to align user needs with the platform’s offerings. Blue Ocean Strategy to identify uncontested market space and differentiate our concept from existing platforms.
In addition to academic projects, I gained real-world experience through my role at SSRE, where I was responsible for selling promotional opportunities. This taught me how to approach companies, pitch value propositions, and negotiate deals. It gave me insight into how businesses operate and helped me build confidence in professional communication and sales.
Working at Studio TOER further strengthened my understanding of the business side of design. I saw up close how creative work is managed and delivered in a professional setting.
Although I am still interested in someday starting a business for myself, I realised that I have more passion for designing and creating knowledge through design itself than for running a business. Sometimes the most interesting questions won’t get answered if you try to answer them for monetary gain. That is the power of fundamental research.
Math, Data & Computing
"But can we prove it?"
Math, data and computing (MD&C) enables designers to analyse and model complex information, structure and validate ideas using data. It makes abstract design concepts measurable and reproducible. It is the technology and realization of information gathered by and for objects.
I had the most trouble with developing this expertise area. The courses calculus and data analytics where big obstacles. Failing calculus 3 years, often made my enthusiasm for the ID program decline and extended my time to graduate significantly. I never had any problems with programming and implementing it, but often found it hard to focus on the theoretical side of MD&C. However, I really liked making sense of sensors. This course allowed me to get a more indepth knowledge of data cleaning and visualization through the use of Python Jupiter scripts.
In the project 3, auto fruit I used sensor data and timestamping to track consumption patterns and inform personalized delivery strategies, gaining insight into behavioural modelling.
In B3.1 Mycelium Research, I developed Python scripts for image recognition and calculation of growth area to quantify fungal growth, learning how to extract and interpret biological data.
Thermocelium, also challenged me to reflect critically on which data to collect and why. I questioned the role of data in design altogether, exploring how slow, relational “data” can shift a user’s perception of temporality and intelligence.
These experiences have shaped my view that data in organic systems is not only a tool for measurement. It can also be a way to uncover subtle patterns, relationships, and behaviours. When working with living materials, I see data as something that can support empathy and interpretation. It helps us understand rather than control. In projects like Thermocelium, I discovered that slow and relational data can shift how users perceive time, presence, and intelligence. This kind of data invites reflection and opens up new ways of designing with the living.
Design research processes
Design research processes is where the most value is created for the designer.

Where you use U&S to generate value for your users, the design research processes is where the most value is created for the designer. Throughout my bachelor, I explored a variety of design research processes, often blending structured experimentation with messy hands-on explorations. I moved towards research-through-design approaches, where creating artifacts became a way to generate knowledge. In projects like Thermocelium and my B3.1Mysignal, I used iterative prototyping, autoethnography, and data analysis to explore complex questions about smartness, material behaviour, and co-habitation. I learned to combine qualitative methods like interviews and journaling with quantitative tools such as Python scripting and sensor data collection. I value design research most when it allows for reflection, when it challenges assumptions, and when it helps me understand both users and systems in a deeper way. For me, the process is not just about validating ideas but about discovering new perspectives through making, observing, and questioning. For me as a designer holds that the process contains the true value.